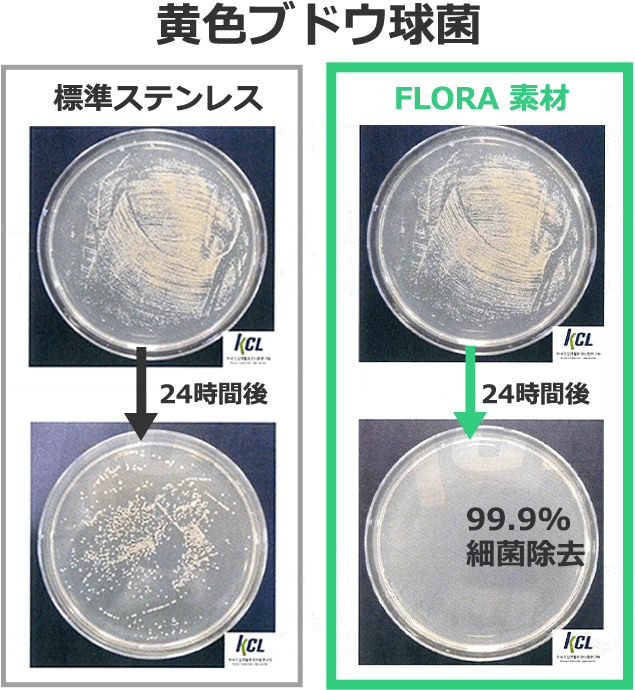

電子レンジOKのステンレスで電子レンジが使えるのはクイッティサンだけ!<口コミ レビュー>

saku料理もなるべく簡単に済ませたいし、洗い物やゴミも極力少なくしたい
収納場所の問題もありますが、食器や保存容器も最小限で済ませているわが家。
調理もできて、そのまま出しても見栄えのいい、保存もできるものがあるととても嬉しい(笑)
そんな中で、電子レンジOKのステンレス保存容器をお試しさせて頂いたので、感想を簡単にまとめたいと思います。
- Cuitisan(クイッティサン)の特徴
- Cuitisanと他の保存容器との比較
- Cuitisanで作ってみた料理
- Cuitisanを使ってみた感想
電子レンジにステンレスは危ないが韓国生まれのクイッティサンは大丈夫な理由とは
今回使わせて頂いたのがこちら

Cuitisanは、CNTコリアという創業40年のステンレス専業で韓国のトップメーカーの製品。
一般家庭の電子レンジでも使用できるよう、特別なステンレスCromoSteel®︎(クロモスティール)を開発採用。
電子レンジのマイクロ波の反射を低減し、電子レンジでの使用を実現。
2019年ドイツにて販売開始し、EU27か国へ展開。その後、オーストラリア、アメリカ、シンガポール、マレーシア、香港、台湾、日本へと広がり、累計で80万個以上を販売するというベストセラーブランドとなる。
ドイツの認証機関 TUV Rherlandから「電子レンジで安全に使用できる」と認証を得て、Cuitisanは各国で愛用される。
2020年には、こだわりの強いフランス人にも認められ、パリで最も有名な百貨店 ギャラリーラファエットで販売開始され人気となる。
日本では2021年から販売開始。
韓国ってステンレス製の食器をよく使っているイメージ。あと、レストランでも。
軽くて丈夫なのに、電子レンジ不可ということで扱いにくい製品でした。
sakuCuitisanはクロモスティールという特別なステンレスだから電子レンジOKなのね!すごい!
Cuitisanフローラの便利な特長7選!
クイッティサンのフローラの特徴をまとめると以下の7つが挙げられます。
開発したCromosteel素材と独自設計により、電子レンジのマイクロ波の反射を低減
いかにも便利そうな特徴です。
わが家は新シリーズであるFROLAの一番使い勝手が良さそうな4点セットを使わせて頂きました。

- No.5 (右上)
- L183xW129xH60mm(580mL)
- No.6(左上)
- L183xW129xH83mm(980mL)
- No.7(左下)
- L220xW157xH65mm(1,100mL)
- No.8(右下)
- L220xW157xH95mm(1,800mL)
Cuitisanと他の保存容器との比較
わが家が使っている保存容器と比較してみると…
| Cuitisan | 野田琺瑯 | iwaki | 陶器 | プラ(イオン) | |
|---|---|---|---|---|---|
| 電子レンジ | 変形の恐れあり | ||||
| オーブン | |||||
| 直火 | |||||
| 食洗機 | フタも可 | ||||
| 耐久性 | 表面のガラスが割れる 欠けた部分がサビる | 割れる | 割れる | 傷つく 変形する |
こう見るとCuitisanは直火がNG以外は耐久性も優れているので扱いやすい印象です◎
\詳細はこちら/
Cuitisanなら電子レンジもオーブン調理もしやすい!お弁当箱にも最適!
直火以外OKだと、下ごしらえから食卓に並ぶまで1つで完結しそうな勢い!
レシピも付属されているので、いくつか作ってみました。
- グラタン
- キーマカレー
- パン
- パスタ
- チーズケーキ
- ティラミス
Cuitisan FROLAでつくるグラタン
レシピにはホワイトソースからつくる材料となっていましたが、わが家は更に時短にしたく市販のマカロニグラタンセットで作りましたw

ブロッコリーは冷凍のがあったので、解凍しておきました。
レンジ解凍からCuitisanを使います♪

解凍されたブロッコリーはよけて置いて、チーズ以外の材料を容器に入れてよく混ぜます。
わが家は豆乳で作ったよ

はじめに600wで8分加熱して、一度混ぜる。
次は5分加熱、混ぜる
最後にブロッコリーを入れて3分加熱

最後にチーズをかけたらそのままトースターへ!5分ほど焼いて完成です。

No.8で作っていたのですが、トースターに入らなかったのでオーブンで仕上げました(苦笑)
浅めのNo.7だと我が家のトースターにも入ったよ○
最初の加熱で少しマカロニは底にくっついてしまいましたが、意外と焦げ付かずにできました。
無印良品のシリコーン調理スプーンのスモールがちょうどよかったです◎
チーズの焦げ付きはあったけど、水でふやかしてからスクレーパーで一発でするりと取れました◎
レンジで完結キーマカレー!ニオイ移り、焦げ付きの心配なし
キーマカレーなら調理、保存、温め直しがNo.8で完結できる!
材料を全て容器に入れて、600w8分→5分→5分で完成!(途中しっかり混ぜてね)

※目玉焼きは別途フライパンで焼いたよ(笑)
わが家はいつも生協のフレーク状のルーを使うので更に混ぜやすく作りやすかったです♪

いつもカレーを作った後は、ホーロー容器に入れて保存→ガスで温め直しをしていたのですが、焦げつきやすさが難点でした。。。
Cuitisanだと電子レンジで温め直しができるので、色移りやニオイ移りの心配もなく手軽に扱えるなと思いました。
焼くスイーツ、冷やすデザートも得意
No.8を使って、チーズケーキも作ってみました。
砕いたビスケットを敷いて、チーズケーキのタネ?を流し込んで後は焼くだけ!簡単!

タネ?を混ぜるのに別途ミキサーを使いましたが、粗熱が取れた後フタをして冷蔵庫で冷やせられるのは便利だなと思いました。

ティラミスを作った際も、ステンレスで冷えやすいので30分足らずで冷たくて美味しいティラミスが食べられました♪

ワンポットパスタ、パンの型までできちゃう
他にもワンポットパスタを作る際もレンジで完結できるので便利だなと思いました。
パスタをレンジで茹でてソースを入れて加熱すればできちゃう。ひとりランチならそのまま食べちゃうので洗い物も最小限(笑)
手ごねパンを作る際も、混ぜる・発酵・焼きまでできちゃうので便利ですね。

\ パン作りはひっそり続けてるよ/
茹でる、焼く、煮る、冷やすをやってみましたが、他にも蒸す調理もできるし、冷凍もOKなのでアイスも安心して作れますね☆
そのまま食卓に並べてもおしゃれだし、残ったらそのまま保存ができて重宝します。
フローラ浅型No.5は子供のお弁当箱にもちょうどよく、衛生的で安心
抗菌効果の高いクイッティサンのステンレスならお弁当箱として使うのも最適!
浅型のNo.5ならおかずを入れるのにちょうどいいです◎
運動会ってことで今日はお弁当〜
— saku|ラク家事探求中 (@sacoolablog3) May 28, 2022
おにぎりは、筍ご飯と山菜おこわとシブい🤣
学年入れ替え制での観覧は観やすくていい✨
児童は二日間運動会になっちゃうけども😅
どちらも天気がよく開催できてよかった😉 pic.twitter.com/Was1CHW5XK
大きい方の浅型No.7ならご飯も一緒に入れられるし、大人も満足できる量だと思います。
冷やした状態でもレンジOKなので、夏の暑い日でもクイッティサンなら安心して持っていけますね。
- 電子レンジは600w以下で連続使用時間10分以内(小分けで加熱する)
- 電子レンジでもフタやラップはしない(変形の恐れあり)
- 庫内には必ず1つの容器のみ入れて使用する
- 自動温めモード使用不可
- ポップコーンや砂糖など水分の少ない食材は直接加熱しないこと
- 取り出す際はミトン必須
\詳細はこちら/
Cuitisanの取扱店は?メリット デメリット感想まとめ
ステンレスなのに電子レンジOKのクイッティサンいかがでしたでしょうか?
感想をまとめると以下の通り!

- 電子レンジ対応可能
- 軽くて丈夫
- 汎用性が高い
- スタッキング収納できてかさばらない
- フタのサイズがバラバラじゃない
- お弁当箱にも使える
- お値段が高い
- レンジ加熱にはコツがいる
- 注意点が多い
似たような性質のホーローをよく使っていましたが、焦げつきやすさやサビなどはちょっと気になっていました。
Cuitisanはステンレスなので傷がつきにくく、焦げ付きもなく温められるのが個人的には感動ものでした。
あと、フタ(容器の上に何か被せる)を使用した調理は不可ですが、レンジでの加熱だと飛び散りそうなのに全然そんなことなくキレイに使えたのが驚きでした。
軽さも感動もの。
No.5と野田琺瑯レクタングルSが同じくらいのサイズですが、重さは圧倒的にNo.5のが軽いです。
大きいサイズ、No.8とレクタングルLと比較すると更に軽さが際立ちます。

収納面でもスタッキングしやすい形状なのですっきりまとまるのがまた助かります。(従来のsignatureシリーズは同サイズだとスタッキングがほとんどできない)
フタもNo.5と6が同サイズ、No.7と8が同サイズなので大きいのと小さいのでフタをする際も見分けやすいのが地味ですがよかったです。

レンジOKのステンレス容器だとお弁当箱としても最適かなと。浅型580mlのNo.5がお弁当箱にちょうど良さそうです。
ステンレスは衛生的でもあるので暑い時期には特に良さそう。
実の弟(独身)が大きなジップロックタッパーにご飯を入れて、レンジで温められるレトルトカレーをかけてお弁当として食べているようなのですが、プラなので汚れ落ちが良くないのとニオイ移り色移りしたり変形したりで何度も買い替えしているご様子。
1100mlのNo.7をプレゼントしようかしらと使ってて思った姉です(笑)
レンジでの加熱にはちょっとコツがいるので慣れるまでに時間はかかるかもしれません。
ご飯を温める際は大さじ1程度の水をふりかけて、他の容器より少し長めに加熱するとふっくら美味しいご飯に温められます。
他にも気をつける点はいくつかあります。
レシピを含めて、冊子が同梱されているので見ながら使えば安心して使えます。慣れれば汎用性も高いので大活躍間違いなしです☆

お値段が高いのが最終的には悩ましいところですが、汎用性あり耐久性にも優れているので一生物と思うとトータル的に考えれば高くはないのかなと個人的に感じました。
取扱店は?公式サイトで購入するのが一番
気になるクイッティサン。どこで手に入るのかというと、実店舗で取り扱っているのは現時点では少ないです。
東京ですと、渋谷ヒカリエ内にあるラ・クッチーナ・フェリーチェというキッチン雑貨店にシグネチャーなら取り扱っています。また、商品自体も若干高いように感じられます。※2022年11月当時
フローラや他の商品がいいという場合は、公式サイトでの購入が一番かと思います。
キャンペーンなどで割引セールを開催していることもあるので、気になる方は公式ショップでチェックしてみてください♪